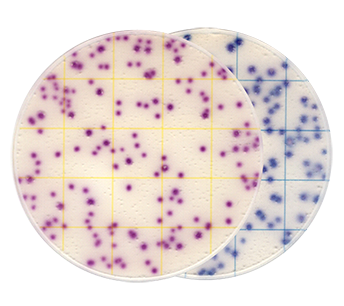
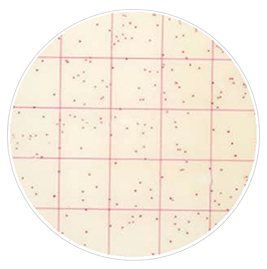
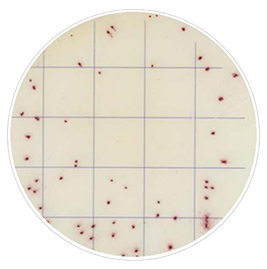
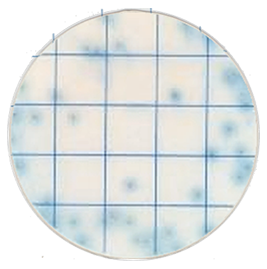
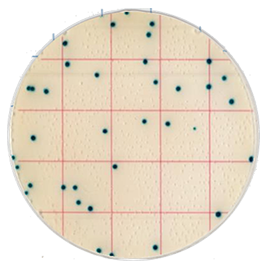
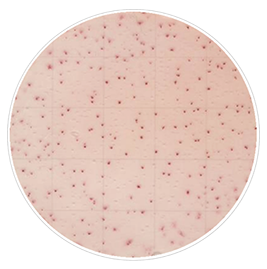
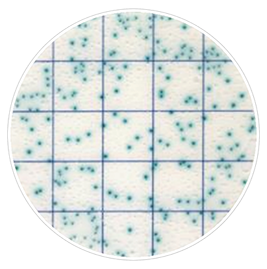
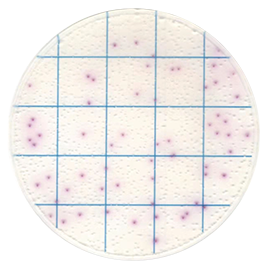
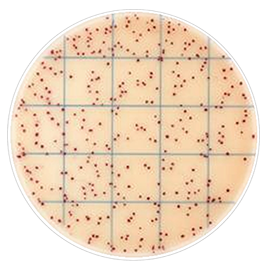
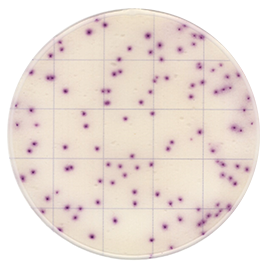
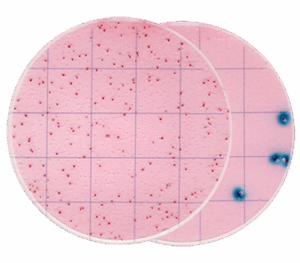
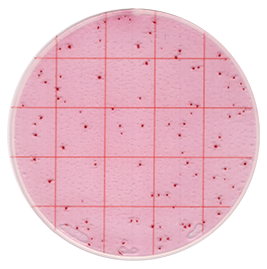
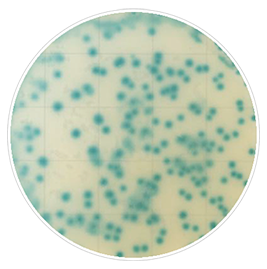
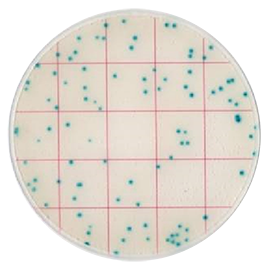
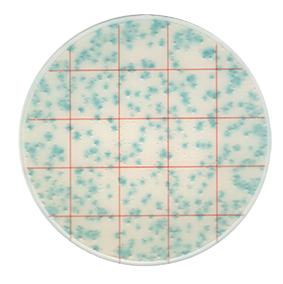
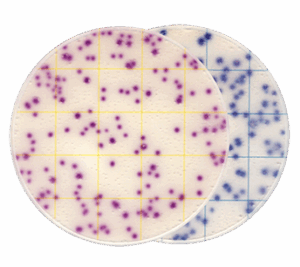
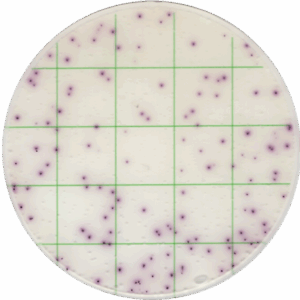
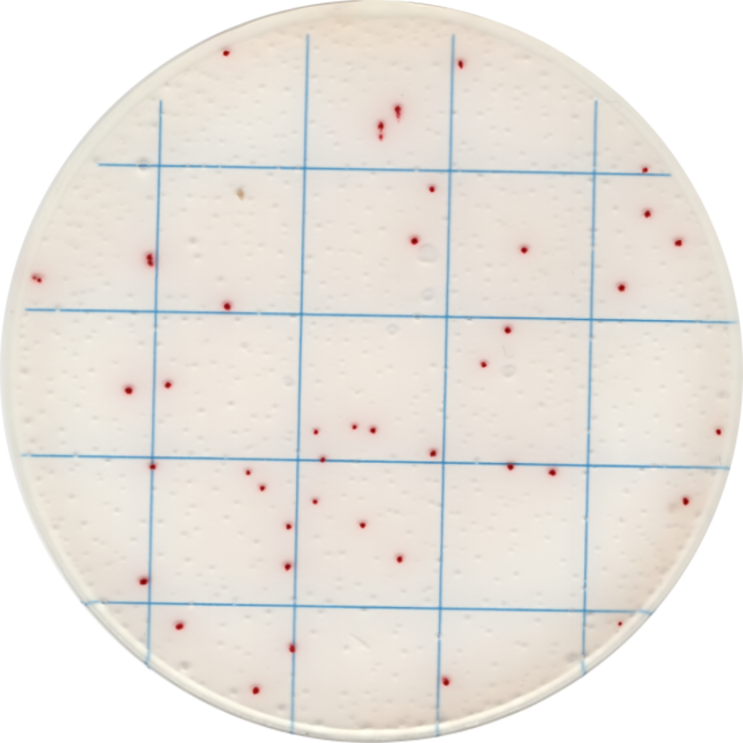
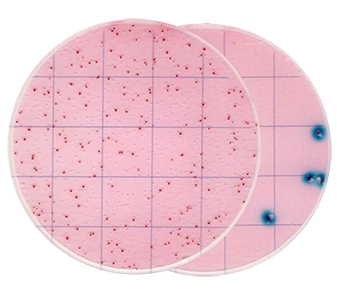
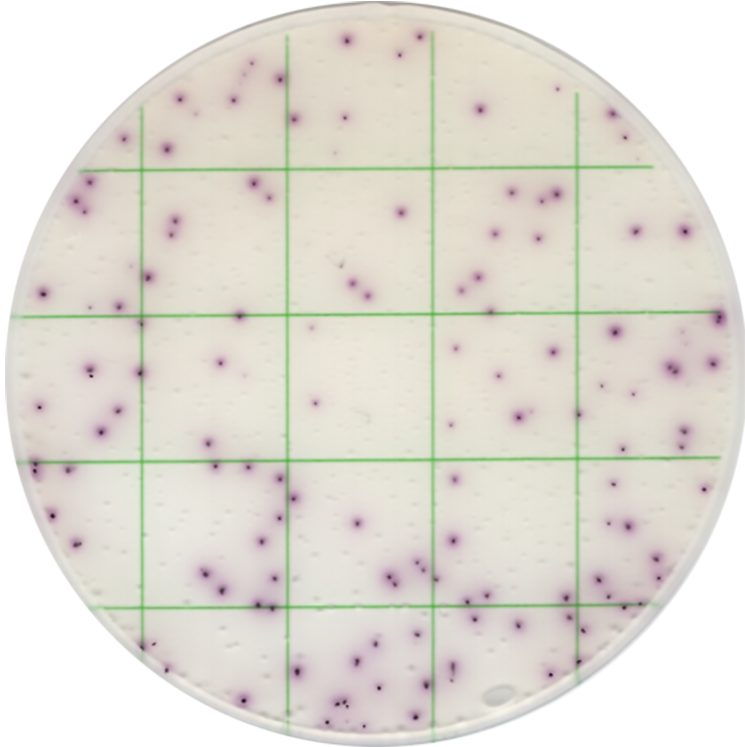

MicroPad GVS:
Tecnologia PRONTA PARA USO que transforma
o controle microbiológico na indústria alimentícia
A microbiologia está diretamente ligada à segurança alimentar. Pesquisas mostram que até 95% dos problemas de segurança alimentar têm origem em microrganismos. Esses contaminantes podem causar deterioração de alimentos, transmissão de doenças e sérios riscos para consumidores e indústrias.
Diante desse desafio, os MicroPads da GVS surgem como uma solução prática, confiável e de uso imediato para a enumeração microbiológica em alimentos.

O que são os MicroPads e como utilizá-los?
Os MicroPads são placas de contagem microbiológica PRONTAS PARA USO. Diferente dos métodos convencionais de cultura, não exigem preparo de meios, reagentes adicionais ou etapas complexas.
O processo é simples e segue quatro passos:

| 1- Preparar a amostra (sólida ou líquida). | 2 – Aplicar 1 ml na placa. | 3- Incubar de acordo com a orientação (geralmente entre 24h e 72h). | 4 – Contar as colônias visíveis no MicroPad. |
Esse fluxo reduz o tempo de trabalho manual, evita erros e garante resultados rápidos e reprodutíveis.
Benefícios dos MicroPads GVS
O uso dos MicroPads oferece diversas vantagens para a rotina de controle microbiológico:
- PRONTO PARA USO: não há necessidade de preparo de meios de cultura.
- Confiabilidade: resultados consistentes, alinhados aos padrões ISO e AOAC.
- Agilidade: menos tempo de incubação e leitura simplificada.
- Redução de custos operacionais: menos trabalho manual e economia de insumos.
- Versatilidade: aplicável em diferentes tipos de alimentos e superfícies.

Grande variedade de modelos disponíveis
A GVS oferece uma ampla linha de MicroPads para diferentes necessidades microbiológicas.
Entre os principais modelos estão:
- Placa de Contagem Aeróbica | Código: MCPG00125
- Placa de Contagem de Staphylococcus aureus | Código: MCPG00225
- Placa de Contagem de Pivot E. Coli/Coliformes | Código: MCPG00325
- Placa de Contagem de Coliformes Pivot | Código: MCPG00425
- Placa de Contagem de Listeria | Código: MCPG00525
- Placa de Contagem de Leveduras e Bolores | Código: MCPG00825
- Placa de Contagem de Coliformes | Código: MCPG01025
- Placa de Contagem de E. Coli/Coliformes | Código: MCPG01125
- Placa de Contagem de Bacillus Cereus | Código: MCPG01325
- Placa de Contagem de Bactérias Ácido-Láticas | Código: MCPG01425
- Placa de Contagem de Salmonella | Código: MCPG01525
- Placa de Contagem de Enterobacteriaceae | Código: MCPG01625
- Placa de Contagem de Geobacillus Stearothermophilus | Código: MCPG01725
- Placa de Contagem de Enterococcus faecalis | Código: MCPG01825
- Placa de Contagem de Bacillus psychrophilus | Código: MCPG01925
- Placa de Contagem de Bacillus Aeróbico | Código: MCPG02425
- Placa de Contagem de Shigella | Código: MCPG02525
- Placa de Contagem de Listeria monocytogenes | Código: MCPG02625
- Placa de Contagem de E. Coli O157 | Código: MCPG02725
- Placa de Contagem de Vibrio parahaemolyticus | Código: MCPG02825
- Placa de Contagem de Bactérias Psicrófilas | Código: MCPG02925

ssa diversidade garante precisão para diferentes microrganismos de interesse em segurança alimentar.
Os produtos são disponibilizados em pacotes com 25 placas.
Principais áreas de aplicação
Os MicroPads são aplicados em setores onde o controle microbiológico é essencial:
- Indústria alimentícia e de bebidas.
- Laticínios.
- Carnes e derivados.
- Produtos de panificação.
- Frutas, legumes e vegetais processados.
- Indústria farmacêutica.
- Controle de qualidade em laboratórios de pesquisa.
Por que escolher os MicroPads da GVS?
A GVS é referência global em filtração. Os MicroPads foram desenvolvidos para oferecer:
- Conformidade com padrões internacionais.
- Soluções práticas para laboratórios e indústrias.
- Resultados rápidos e confiáveis.
- Suporte técnico especializado.
Com os MicroPads, o controle microbiológico se torna mais ágil e seguro, garantindo a qualidade dos alimentos e a confiança do consumidor.
A segurança alimentar depende de métodos de detecção eficientes e confiáveis.
Os MicroPads da GVS simplificam esse processo, oferecendo praticidade, rapidez e precisão para indústrias que não podem correr riscos com a contaminação microbiana.